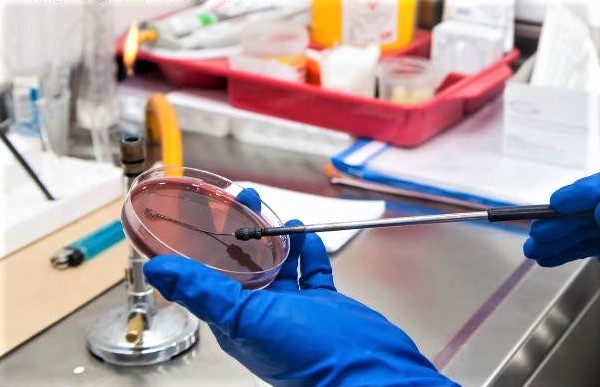
8 'tips' para cuidar la salud pulmonar

Por: Dr. Benjamin Lee
NewYork-Presbyterian Queens
El cáncer de pulmón es la principal causa de muerte por cáncer y el segundo cáncer más común entre hombres y mujeres en los Estados Unidos, según los CDC.
En reconocimiento al Mes de Concientización sobre el Cáncer de Pulmón, conmemorado en noviembre, el Dr. Benjamin Lee, jefe de cirugía torácica en NewYork-Presbyterian Queens, comparte consejos sobre cómo prevenir y detectar el cáncer de pulmón y otras enfermedades respiratorias.
1. No fume cigarrillos
El humo del cigarrillo puede estrechar los conductos de aire y dificultar la respiración, causando inflamación crónica, que puede conducir a bronquitis crónica.
Con el tiempo, el humo del cigarrillo destruye el tejido pulmonar y puede desencadenar cambios que se convierten en cáncer. Si fuma, nunca es demasiado tarde para hablar con su médico acerca de dejar de fumar.
2. Coma alimentos ricos en vitamina C
Un reciente estudio de la Escuela de Salud Pública Bloomberg de Johns Hopkins muestra que una mayor ingesta de frutas ricas en antioxidantes y flavonoides, como manzanas y tomates, se asoció con una disminución más lenta de la función pulmonar, especialmente entre ex fumadores.
Comer alrededor de cuatro porciones de fruta por día puede ayudar a mantener la salud a largo plazo de sus pulmones.
3. Prevenga la infección
Las infecciones respiratorias pueden volverse muy graves rápidamente, pero hay pequeños hábitos que puede incorporar a su vida todos los días para protegerse.
Siempre lávese las manos, cepíllese los dientes dos veces al día, vacúnese contra la gripe y evite las multitudes durante la temporada de resfriados y gripe.
4. Practique técnicas de respiración
Con el tiempo, perdemos la capacidad de inhalar la cantidad máxima de oxígeno que necesitamos para nuestra salud.
Practique ejercicios de respiración como la respiración abdominal, que pueden ayudarlo a mantener una postura correcta y respirar por completo.
5. Manténgase libre de estrés
Si sufre de estrés crónico, intente aprender la mejor táctica para reducir sus niveles de estrés, como escuchar música clásica relajante o meditar.
6. Minimice tiempo en áreas contaminadas
La contaminación del aire puede afectar negativamente su salud pulmonar y la de su familia. Verifique los pronósticos diarios de contaminación del aire en su área para conocer cuando el aire no es saludable en su comunidad.
7. Ejercicio
El ejercicio aeróbico puede ayudar a mejorar la capacidad pulmonar, es decir, la cantidad de oxígeno que toma con cada respiración.
Trate de incluir algunos entrenamientos de resistencia en sus rutinas habituales, como caminar cuesta arriba durante su caminata diaria o usar la configuración de intervalo al correr en la cinta de correr.
8. Visite a su médico
La EPOC y otras enfermedades pulmonares a menudo pueden pasar desapercibidas hasta que sea demasiado tarde, pero ver a su médico anualmente puede ayudar a detectar estas enfermedades temprano y tratarlas de manera efectiva.
- Más de Salud : Cinco consejos nutricionales para enfrentar la Diabetes

















